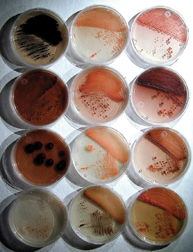

Many drugs, including the antibiotic streptomycin, are derived from soil microbes called actinomycetes. Lately, however, scientists have been wondering whether they have wrung out all of the drugs possible from these bacteria.
Now, William Fenical and his colleagues at the Scripps Institution of Oceanography in La Jolla, Calif., have found a large source of previously unknown strains of actinomycetes that may make chemicals with antibiotic or cancer-fighting properties.
Fenical discovered the new bacteria, which he dubs Salinospora, in deep ocean sediments collected from all over the globe. In preliminary benchtop tests, many of the 2,500 Salinospora strains identified by Fenical produced potentially therapeutic chemicals.
In additional studies, Fenical and his coworkers determined the chemical structure of one such molecule–salinosporamide A. In test tubes, the molecule strongly inhibited the growth of some cancer cells from human colon, lung, and breast tissues. The researchers describe their results in the Jan. 20 Angewandte Chemie International Edition.
“This is the tip of an iceberg,” says Fenical. Salinosporamide A and molecules from other strains of Salinospora might serve as new tools for studying cancer or even as therapeutic drugs themselves one day, he says.
****************
If you have a comment on this article that you would like considered for publication in Science News, please send it to editors@sciencenews.org.